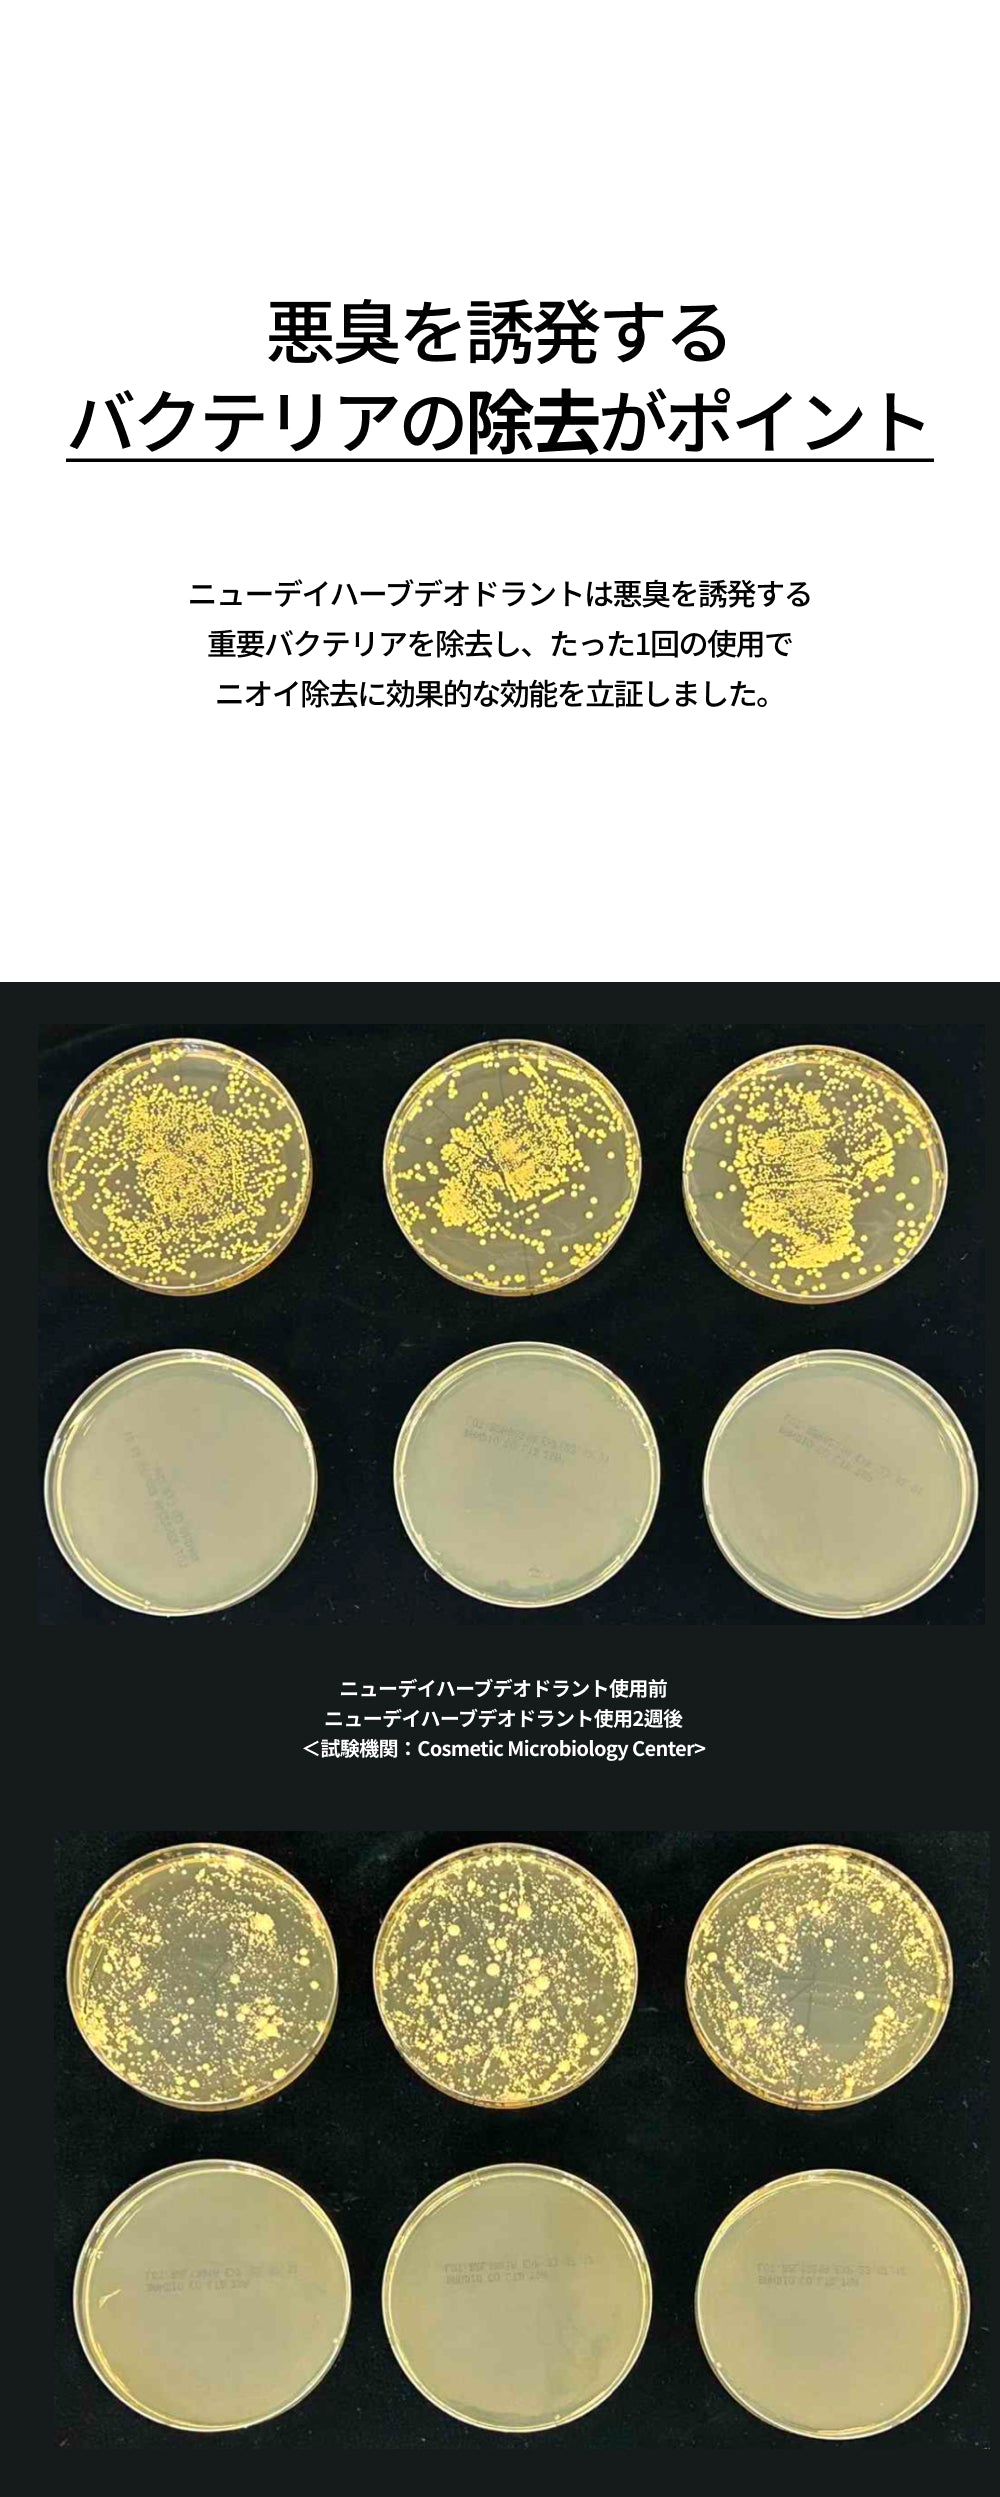

Rated 4.9 out of 5 stars
15 レビュー
New Day | Herbal Deodorant
ハーブデオドラントジェルで、自信に満ちたハツラツとした1日をスタートしてください。
- 長時間持続する、爽やかなベルガモットの香り
- 深い保湿と保護機能
- ワキの色素沈着の減少
- 酸化防止機能
¥2,900
配送情報
弊社の商品は全て韓国から直送しております。 注文処理時間は1日かかります。 発送にはさらに4~5日かかります。私たちはできるだけ早くあなたの注文を送るために最善を尽くしています。お待ちいただきありがとうございます。
全成分リスト
水、アルコール、C12-14アルコキシ-12、プロパンジオール、1,2-ヘキサンジオール、ヒドロキシプロピルメチルセルロース、香料、ベンジルベンゾエート、ブチレングリコール、α-イソメチルイオノン、リナロール、リモネン、エチルヘキシルグリセリン、ウンダリア・ピナチフィダエキス、塩化ナトリウム、ユーゲノール、シトラール、デキストリン、ゲラニオール、テオブロマ・カカオ(ココア)エキス、コプチス・ジャポニカ根エキス、フコイダン、アスコルビン酸、シトラス・オーランティウム・ベルガモット果実油